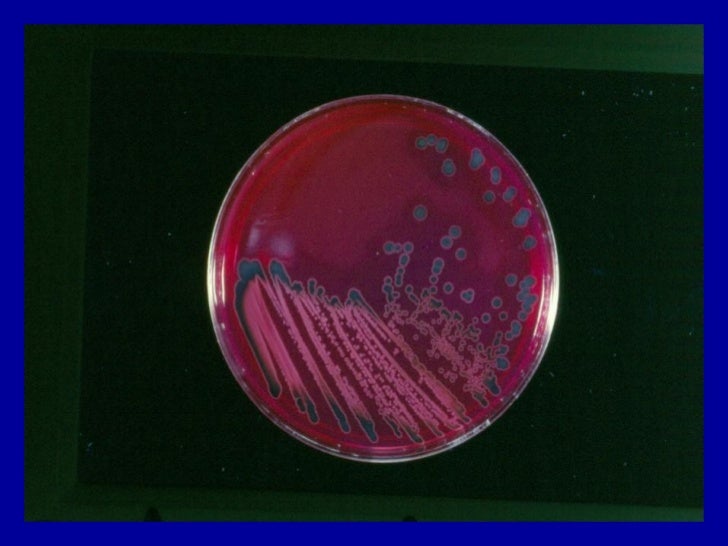

Shigella sonnei: микроскопические изображения

Раздел: Другие животные